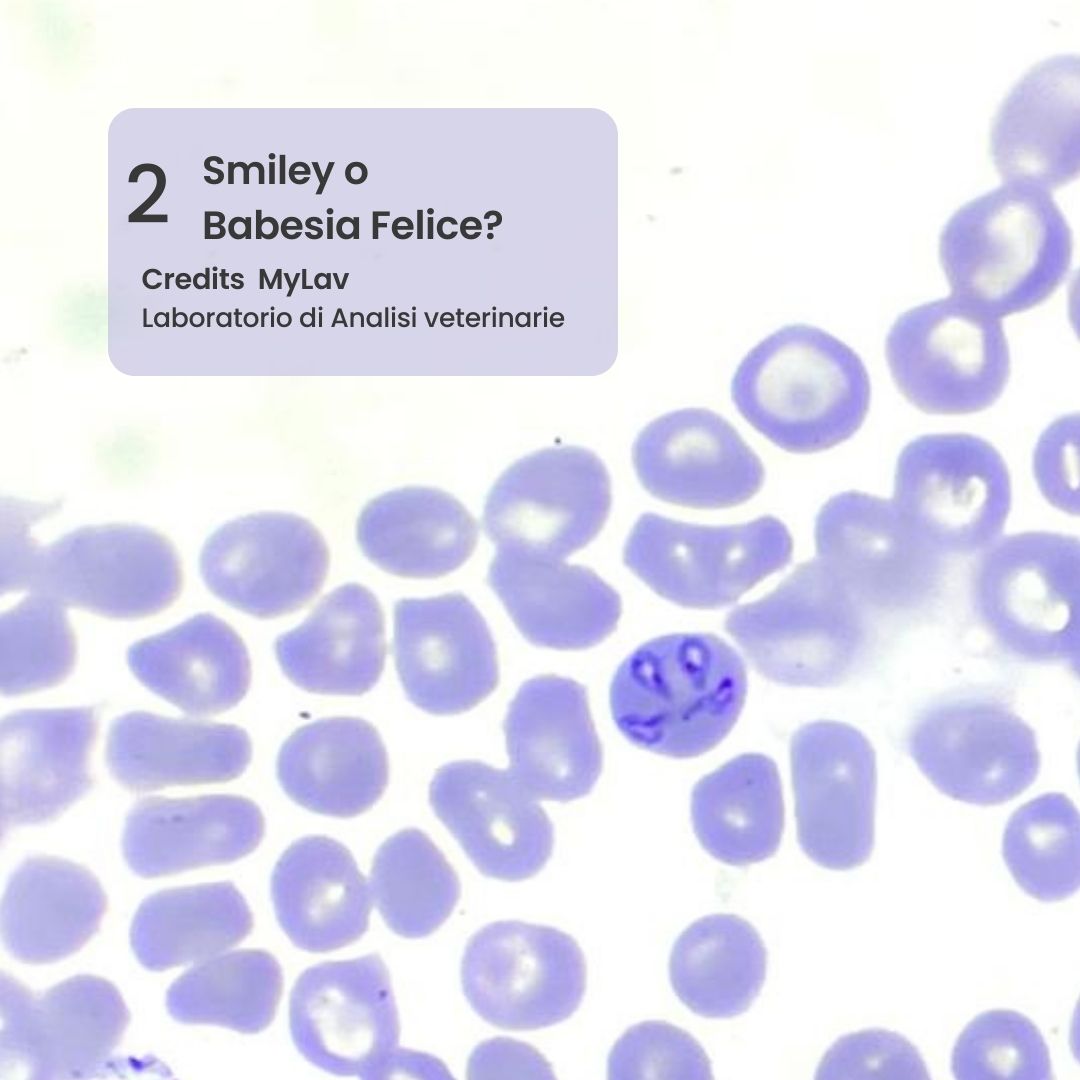

L’ultima campagna lanciata da MYLAV “Se non lo vedi, non è detto che non ci sia” riguarda l’importanza degli esami da laboratorio. Esistono, infatti, una serie di patologie come alcune micosi che possono non dare particolari sintomi evidenti e che quindi possono sfuggire a un occhio non esperto. Non tutti i sorrisi sono però uguali: uno Smiley può rivelare una Babesia, ovvero un protozoo trasmesso dalle zecche. Così come, dietro ad un insolito neutrofilo a forma di cuore, può esserci la presenza di un processo infiammatorio in atto. Il vedere un marziano o una violetta può rivelare forme tumorali, un campo di margherite far scoprire un colon patologico.
Appare qui ancora più evidente l’importanza dei controlli periodici e delle visite di routine dal proprio veterinario di fiducia. Il laboratorio veterinario MYLAV, grazie al lavoro dei propri medici veterinari citologi, ha raccolto sei simpatiche e significative immagini al microscopio di alcune tra le problematiche che possono colpire i nostri animali e che possono essere rivelate grazie ad approfondimenti laboratoristici molto utili. A volte quello che sembra un semplice mazzo di fiori nasconde un sarcoma; non sempre, quindi, se una cosa non si vede non è detto che non ci sia.
Le patologie che possono colpire i nostri amici a quattro zampe sono molteplici.
Neutrofilo bandato. Specifica cellula del sangue immatura: quando vi è una grossa richiesta di cellule “soldato”, questo può capitare in corso di flogosi e il midollo li rilascia prima che siano completamente maturi segnalando così che qualcosa è in corso con un “esercito” in attività.
La Babesiosi è una grave malattia che può anche risultare fatale. I cani sono a rischio di infestazione da zecche, soprattutto durante le passeggia. Le zecche assumono il protozoo da animali infetti e possono trasmetterlo a cani sani. Una volta in circolo, la Babesia attacca e distrugge i globuli rossi, causando gravi anemie e complicazioni, che possono anche risultare fatali.
I tumori mesenchimali colpiscono i cani come i gatti e possono interessare diversi tessuti. In molti casi possono essere maligni e quindi una diagnosi precoce è estremamente importante.
Le micosi sono malattie causate da funghi che colpiscono sia gli animali che l’uomo. Possono colpire sia la cute che i tessuti e gli organi più profondi ed essere causa di gravissime malattie difficili da curare.
Il Colon patologico si presenta al microscopio come un grazioso campo di margherite, in realtà dice molto. Nel cane, benché le patologie infiammatorie del colon siano una causa comune di diarrea del grosso intestino, spesso l’eziologia precisa non viene identificata e la diagnosi è basata proprio sulla descrizione istopatologica ovvero si rivela osservando al microscopio un pezzettino di intestino (biopsia).
I sarcomi rappresentano un gruppo ampio ed eterogeneo di tumori per i quali la prognosi è generalmente sfavorevole se non diagnosticati in tempo. La diagnosi precoce della malattia attraverso lo screening sistematico dei soggetti a rischio porterebbe probabilmente a un miglioramento delle opportunità terapeutiche perché potrebbe consentire la rimozione di tumori primitivi piccoli e ancora localizzati.
In ambito laboratoristico veterinario si è assistito ad una vera e propria evoluzione per tipologia di esami che possono essere richieste dai medici veterinari clinici per aiutarli a fare diagnosi. L’esame più importante è sicuramente l’emocromo, che permette di valutare la composizione delle cellule del sangue e la concentrazione dell’emoglobina. Vi è poi la biochimica clinica, che misura la concentrazione di sostanze chimiche molto importanti per valutare lo stato di salute degli animali e l’esame delle urine che permette, ad esempio, di fare anche esami colturali microbiologici per ricercare eventuali infezioni urinarie.
Tendenzialmente, un check up annuale è raccomandato. Negli anziani è consigliabile farlo due volte l’anno. Nei cuccioli e nei giovani adulti, non è così fondamentale il check up generale, è però importante escludere eventuali parassiti almeno in quattro occasioni il primo anno.
“Quasi tutto quello che viene fatto nei laboratori degli ospedali umani possiamo ormai farlo anche nei laboratori veterinari più attrezzati e all’avanguardia per salvaguardare la salute dei nostri amici animali” spiega il Dott Guglielmo Giordano, Amministratore di MYLAV.